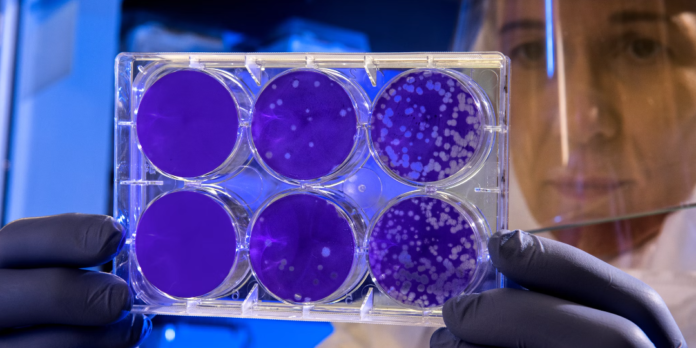

Primul țesut cerebral imprimat 3D din lume a fost dezvoltat de cercetători. Acesta crește și se dezvoltă similar cu țesutul natural al creierului, porivit neurosciencenews.
Tehnica utilizează o abordare de stratificare orizontală și o cerneală bio moale. Neuronii pot astfel să se inteconecteze și să formeze rețele neuronale similare celor din creierul uman.
Realizarea poate duce la noi descoperiri în ceea ce privește tulburările neurologice și de neurodezvoltare. Printre acestea se numără bolile Alzheimer și Parkinson.
„Acesta ar putea fi un model extrem de puternic care să ne ajute să înțelegem modul în care celulele creierului și părți ale creierului comunică la oameni”, a spus Su-Chun Zhang. El este profesor de neuroștiință și neurologie la Centrul Waisman din UW-Madison.
„Ar putea schimba modul în care privim biologia celulelor stem, neuroștiința și patogeneza multor tulburări neurologice și psihiatrice.”, a adăugat el.
Primul țesut cerebral imprimat 3D
Metodele de imprimare au limitat succesul încercărilor anterioare de a imprima țesutul cerebral. Grupul din spatele noului proces de imprimare 3D a descris descoperirea în Cell Stem Cell.
În loc să folosească abordarea tradițională de imprimare 3D, stivuirea straturilor pe verticală, cercetătorii au dezvoltat țesutul pe orizontală. Ei au situat celulele creierului, neuroni crescuți din celule stem pluripotente induse, într-un gel de „bio-cerneală” mai moale decât în cercetările anterioare.
„Țesutul are încă suficientă structură pentru a se menține legat, dar este suficient de moale pentru a permite neuronilor să crească unul în celălalt și să înceapă să comunice între ei”, a spusZhang.
Celulele sunt așezate una lângă alta ca niște creioane așezate unul lângă celălalt pe o masă.
Yan a spus că țesutul „e relativ subțire, iar neuronii pot obține mai ușor oxigen și nutrienți din mediul de creștere”.
Neuronii comunică, trimit semnale, interacționează între ei prin neurotransmițători și chiar formează rețele adecvate cu celule suport care au fost adăugate țesutului imprimat.
„Chiar și atunci când am imprimat celule diferite aparținând diferitelor părți ale creierului, acestea au fost încă capabile să vorbească între ele într-un mod foarte special și specific.”, a spus Zhang.
Tehnica de imprimare oferă precizie – control asupra tipurilor și aranjamentului celulelor – care nu se găsește în organoizii creierului, organe miniaturale folosite pentru a studia creierul. Organoizii cresc cu mai puțină organizare și control.
„Laboratorul nostru este foarte special prin faptul că suntem capabili să producem aproape orice tip de neuroni în orice moment. Apoi îi putem pune împreună aproape în orice moment și în orice mod ne place”, a mai zis Zhang.
Studierea anumitor boli
Țesutul cerebral imprimat ar putea fi folosit pentru a studia legăturile dintre celulele din sindromul Down, interacțiunile dintre țesutul sănătos și țesutul vecin afectat de Alzheimer, pentru a testa noi candidați la medicamente sau chiar pentru a urmări creșterea creierului.
„În trecut, ne-am uitat adesea la un singur lucru, ceea ce înseamnă că deseori ne-au lipsit unele componente critice. Creierul nostru funcționează în rețele. Vrem să imprimăm țesutul cerebral în acest fel, deoarece celulele nu funcționează de la sine. Ele vorbesc una cu alta. Așa funcționează creierul nostru și trebuie studiat împreună astfel pentru a-l înțelege cu adevărat”, spune Zhang.
Noua tehnică de imprimare ar trebui, de asemenea, să fie accesibilă mai multor laboratoare. Nu necesită echipamente speciale de bio-imprimare sau metode de cultură pentru a menține țesutul sănătos. Acesta poate fi studiat în profunzime cu microscoape și tehnici standard de imagistică.
Cercetătorii ar dori totuși să-și îmbunătățească în continuare bio-cerneala și să-și rafineze echipamentul pentru a permite orientări specifice ale celulelor în țesutul imprimat.